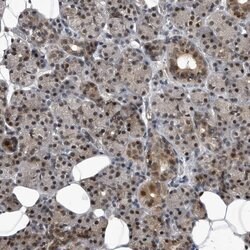
Invitrogen RAD23B Polyclonal Antibody 100 &mu;L | Buy Online | Invitrogen&trade; | Fisher Scientific

missing translation for 'onlineSavingsMsg'
Learn More
Learn More
Description
Immunogen sequence: LPALLQQIGR ENPQLLQQIS QHQEHFIQML NEPVQEAGGQ GGGGGGGSGG IAEAGSGHMN YIQVTPQE Highest antigen sequence identity to the following orthologs: Mouse - 88%, Rat - 91%.
The protein encoded by this gene is one of two human homologs of Saccharomyces cerevisiae Rad23, a protein involved in the nucleotide excision repair (NER). This protein was found to be a component of the protein complex that specifically complements the NER defect of xeroderma pigmentosum group C (XP-c) cell extracts in vitro. This protein was also shown to interact with, and elevate the nucleotide excision activity of 3-methyladenine-DNA glycosylase (MPG), which suggested a role in DNA damage recognition in base excision repair. This protein contains an N-terminal ubiquitin-like domain, which was reported to interact with 26S proteasome, and thus this protein may be involved in the ubiquitin mediated proteolytic pathway in cells.

Specifications
Specifications
| Antigen | RAD23B |
| Applications | Immunohistochemistry (Paraffin), Western Blot |
| Classification | Polyclonal |
| Concentration | 0.1 mg/mL |
| Conjugate | Unconjugated |
| Formulation | PBS with 40% glycerol and 0.02% sodium azide; pH 7.2 |
| Gene | Rad23b |
| Gene Accession No. | P54727 |
| Gene Alias | 0610007D13Rik; AV001138; HHR23B; HR23B; Mhr23b; P58; RAD23 homolog B (S. cerevisiae); RAD23 homolog B, nucleotide excision repair protein; RAD23, yeast homolog of, B; RAD23B; RAD23b homolog; RAD23b homolog (S. cerevisiae); UV excision repair protein RAD23 homolog B; XP-C repair complementing complex 58 kDa; XP-C repair complementing protein; XP-C repair-complementing complex 58 kDa protein |
| Gene Symbols | Rad23b |
| Show More |
Product Title
By clicking Submit, you acknowledge that you may be contacted by Fisher Scientific in regards to the feedback you have provided in this form. We will not share your information for any other purposes. All contact information provided shall also be maintained in accordance with our Privacy Policy.
Spot an opportunity for improvement?